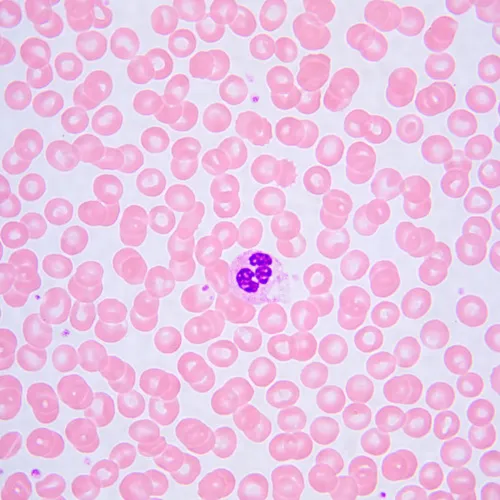
a fotón:  MAGUS Bio 240B biológiai mikroszkóp,  25

MAGUS Bio 240B biológiai mikroszkóp
Nagyítás: 40x–1000x. Kétszemlencsés fejrész, kóddal ellátott revolverfej, sík-akromatikus objektívek, 3 W-os LED-világítás, intelligens világításvezérlő rendszer
| Termékazonosító | 83476 |
| Márka | MAGUS |
| Szavatosság | 5 év |
| EAN | 5905555019420 |
| A csomag méretei (HxSzxM): | 45x30x65 cm |
| Szállítási súly | 9.5 kg |
A MAGUS Bio 240B oktatási mikroszkópot professzionális képzésre alakítottuk ki. Segítségével áteső fényben végezheti el a szükséges vizsgálatokat, a világos látóterű módszert alkalmazva, továbbá átlátszó és áttetsző biológiai mintákat tanulmányozhat vele. A mikroszkóp négy objektíves, intelligens megvilágítással ellátott, kódolt, forgatható revolverfejjel van felszerelve: az egyes objektívekhez igazítottuk a fényerejét. A készülék kompakt, kényelmesen mozgatható és tárolható.
A fejet két szemlencse befogadására terveztük, végtelenre korrigált optikai rendszer található benne. A fej tubusai teljesen elfordulnak a tengelyeik körül. A szemtávolság a felhasználó magasságához igazítható. 2 standard, 10x/20 mm-es szemlencse tartozik a mikroszkóphoz. Gumi szemkagyló is található a készletben, a szemüveges felhasználók számára: a szemkagylók egyfajta réteget alkotnak a szemüveg lencséi és a mikroszkóp szemlencséi között, továbbá a kopástól, karcolásoktól és sérülésektől is védik az optikát. Mindegyik tubus dioptriaállító gyűrűvel van ellátva: a felhasználó a fókuszt a saját látásának megfelelően állíthatja be. Ez a funkció különösen hasznos az olyan kutatók számára, akiknél a két szemlátása eltér, mivel az egyes szemlencséket egymástól függetlenül is be lehet állítani. Ha a mikroszkóphoz digitális fényképezőgépet kell csatlakoztatni, akkor a fényképezőgép az egyik szemlencse eltávolításával az egyik tubusba helyezhető.
A revolverfejen négy nyílás található az objektívek befogadására. A revolver rész a mikroszkóp „belseje felé” irányul: a kutató a munkaobjektumot maga előtt látja, míg a többi objektum a távolban van. Az az előnye ennek az elrendezésnek, hogy nagy szabad munkaterület áll rendelkezésre a felhasználó előtt. Objektívváltáskor a fényerősség objektívváltáskor általában ingadozni szokott. Ez erősen megterheli a szemet, és fáradtsághoz vezet. A MAGUS Bio 240B mikroszkóp intelligens világításvezérlő rendszerrel van felszerelve, hogy ezt a kellemetlen hatást el lehessen kerülni: a felhasználónak egyszer kell beállítania az egyes objektívek fényerejét, ezután a megvilágítás az objektívek váltásakor automatikusan változik. További kényelmet ad, hogy az objektívek váltásakor a felhasználónak nem kell időt töltenie a világítás beállításával.
A mikroszkóp olyan fókuszáló rendszerrel van felszerelve, amelyen koaxiálisan elhelyezett durva- és finombeállító gombok találhatók. Ezek a váz alján és az állvány két oldalán helyezkednek el, ami lehetővé teszi a felhasználó számára, hogy kényelmes pozíciót vegyen fel a fókusz beállításnál. A bal oldalon van a durva fókuszállító szorítógomb, amellyel a kép gyorsan beállítható az objektívváltás után. A jobb oldalon található az a gyűrű, amellyel az Ön igényei szerint módosítható a durva fókuszáló út merevsége.
A tárgyasztal szíjhajtású mechanizmussal van felszerelve. Segítségével a minta gördülékenyen tud mozogni az objektívek alatt.
Az Abbe-kondenzor a tárgyasztal alatt rögzítettük, valamint gyárilag középre és a megfelelő függőleges helyzetbe állítottuk: a telepítésre és konfigurálásra a felhasználónak nem szükséges időt és energiát fordítania. A kondenzor numerikus rekesznyílásának értéke 1,25. Fogantyújával az íriszmembránt lehet beállítani. A kondenzorról színes objektívnagyítási jelek olvashatók le: a fogantyú helyzetét a kontrasztos kép érdekében az éppen használt objektívnek megfelelően kell beállítani.
A mikroszkóp áteső fényben működik. 3 W-os LED égő biztosítja a világítást. Színhőmérséklete 3000 K és 7000 K között állítható, így a vizsgált tárgy jellemzőihez lehet igazítani a megvilágítást. A világítás üzemideje 50 000 óra.
A modell másik, jól hasznosítható tulajdonsága az LCD-képernyő. Ezen jelennek meg a működési paraméterek: az aktív objektív nagyítási értéke, a megvilágítási hőmérséklet és a működési mód.
A mikroszkóp az oldalsó fogantyúk segítségével mozgatható. A készüléket úgy terveztük meg, hogy a váz hátsó falán legyen elrejtve a kábel és a hálózati adapter is. Ez esztétikus, biztonságos és kényelmes is, ha a mikroszkóp tárolására és szállítására kerül sor.
Főbb jellemzők:
- Mikroszkóp áteső fényben történő vizsgálatokhoz, valamint átlátszó és áttetsző minták tanulmányozására
- Kódolt, 4 objektíves forgó revolverfejjel és automatikus fényerőszabályozású, intelligens világítással rendelkezik
- Beépített kijelző is található rajta, ami megjeleníti az aktuális működési paramétereket
- A kondenzort a megfelelő függőleges helyzetben rögzítettük és középre állítottuk. A gyors beállításhoz az objektívet nagyítási jelölésekkel láttuk el
- A kétszemlencsés fejre digitális videokamera is felszerelhető
- Az egyes tubusok dioptriaállító gyűrűvel vannak ellátva. Ez a jellemző különösen hasznos az eltérő látásélességű felhasználók számára
- A mikroszkóp kompakt, ergonomikus formájú, ezért kényelmesen mozgatható és tárolható
A készlet tartalma:
- Áteső fényforrású állvány, fókuszáló mechanizmus, tárgyasztal, kondenzortartó, revolverfej
- Abbe kondenzor
- Kétszemlencsés fejrész
- Végtelen síkú akromatikus objektív: 4x/0,10
- Végtelen síkú akromatikus objektív: 10x/0,25
- Végtelen síkú akromatikus objektív: 40x/0,65 (rugós szerkezetű)
- Végtelen síkú akromatikus objektív: 100x/1,25 olaj (rugós szerkezetű)
- 10x/20 mm-es szemlencse hosszú szemtávolsággal (2 db)
- Szemlencse szemkagylója (2 db)
- Fényszűrő
- Hálózati adapter és kábel mikroszkóphoz
- Porvédő
- Felhasználói kézikönyv és garanciajegy
Igény esetén rendelkezésre áll:
- Digitális kamera
- Kalibrációs tárgylemez
- C-foglalat adapter
- Monitor
| Termékazonosító | 83476 |
| Márka | MAGUS |
| Szavatosság | 5 év |
| EAN | 5905555019420 |
| A csomag méretei (HxSzxM): | 45x30x65 cm |
| Szállítási súly | 9.5 kg |
| Típus | biológiai, fény/optikai |
| Mikroszkóp fejrész típusa | binokuláris |
| Fejrész | Gemel fejrész (Seidentopf, 360°-ban forgatható) |
| Fej dőlésszöge | 30° |
| Nagyítás foka, x | 40 — 1000 |
| Szemlencsecső átmérője, mm | 23.2 |
| Szemlencsék | 10x/20 mm, nagy szemtávolság |
| Objektívek | végtelen síkú akromatikus: 4x/0,10; 10x/0,25; 40xs/0,65; 100xs/1,25 olaj; parfokális távolság: 45 mm |
| Forgó tárgylencsefoglalat | 4 objektív, kódolt |
| Pupillatávolság (PD), mm | 47 — 75 |
| Tárgyasztal, mm | 180x130 |
| Tárgyasztal mozgatási tartomány, fókuszálási szerkezettel, mm | 74/30 |
| Tárgyasztal | kéttengelyes mechanikus tárgyasztal, pozicionáló állvány nélkül |
| Szemlencse dioptriabeállítás, dioptria | ±5D mindkét tubuson |
| Szemlencse dioptriabeállítás | ✓ |
| Kondenzor | Abbe kondenzor (1,25 N.A.) állítható fényrekesszel és színkódolt objektívnagyítással |
| Diafragma | állítható rekesznyílás |
| Fókusz | koaxiális, durvafókusz (17 mm, 37,7 mm/kör, rögzítőgombbal és feszültségszabályozó gombbal) és finomfókusz (0,002 mm, 0,2 mm/kör) |
| Megvilágítás | LED |
| Fényerősség-szabályozás | ✓ |
| Tápellátás | 100—240 V, 50/60 Hz, a váltóáram/egyenáram hálózati adapter egy erre a célra kialakított alzatban található az állvány hátulján, váltakozóáramú hálózat |
| Fényforrás típusa | 3 W-os LED, színhőmérséklet-állítással (3000–7000 K) |
| Fényszűrők | igen |
| Kiegészítő | alvó mód, automatikus fényerőállítás objektívváltáskor, eco mód, állapotkijelzés LCD-képernyőn |
| Felhasználói szint | gyakorlott felhasználók, szakemberek |
| Az összeszerelés és a telepítés nehézségi szintje | bonyolult |
| Használat | laboratóriumi/orvosi |
| Fényforrás elhelyezkedése | alsó |
| Vizsgálati módszer | világos látótér |
| Tok/doboz/táska a készletben | porvédő |
és letöltések